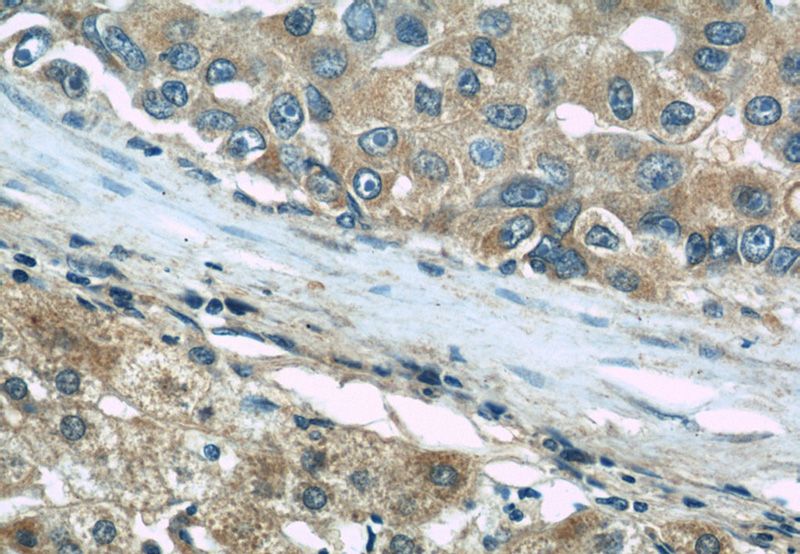
Immunohistochemical of paraffin-embedded human liver cancer using Catalog No:116022(BIGH3 antibody) at dilution of 1:50 (under 40x lens)
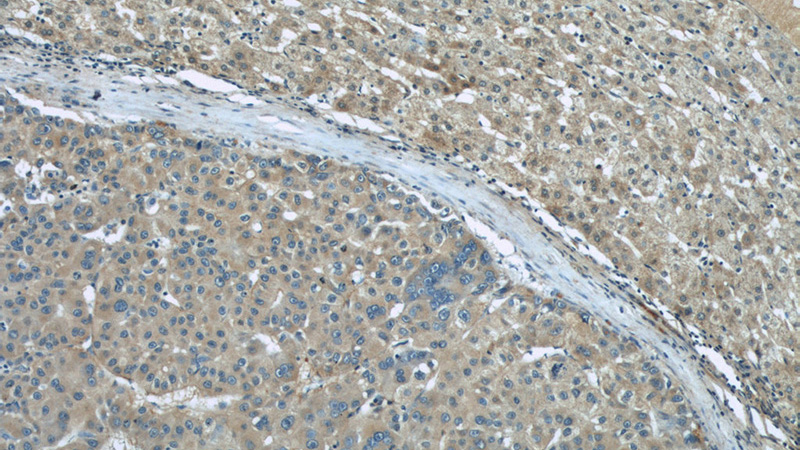
Immunohistochemical of paraffin-embedded human liver cancer using Catalog No:116022(BIGH3 antibody) at dilution of 1:50 (under 10x lens)
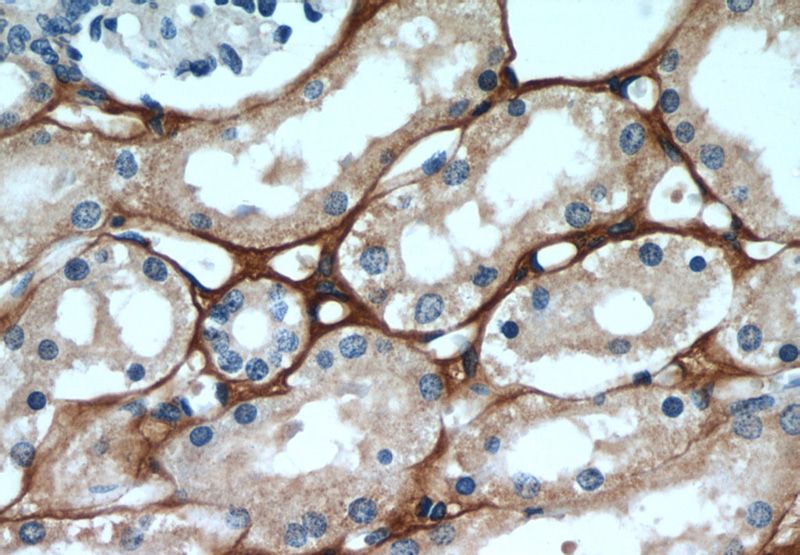
Immunohistochemical of paraffin-embedded human kidney using Catalog No:116022(BIGH3 antibody) at dilution of 1:50 (under 40x lens)
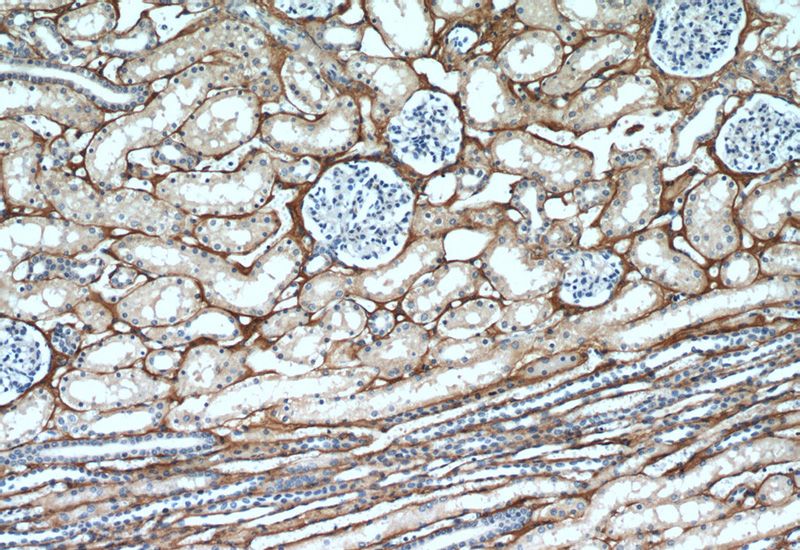
Immunohistochemical of paraffin-embedded human kidney using Catalog No:116022(BIGH3 antibody) at dilution of 1:50 (under 10x lens)

-
Product Name
TGFBI / BIGH3 antibody
- Documents
-
Description
TGFBI / BIGH3 Rabbit Polyclonal antibody. Positive WB detected in Y79 cells, HeLa cells, human kidney tissue, mouse eye tissue, mouse liver tissue. Positive IP detected in HeLa cells. Positive IHC detected in human liver cancer tissue, human kidney tissue, human pancreas cancer tissue. Observed molecular weight by Western-blot: 64 kDa
-
Tested applications
ELISA, IP, IHC, WB
-
Species reactivity
Human,Mouse,Rat; other species not tested.
-
Alternative names
Beta ig h3 antibody; BIGH3 antibody; CDB1 antibody; CDG2 antibody; CDGG1 antibody; CSD antibody; CSD1 antibody; CSD2 antibody; CSD3 antibody; EBMD antibody; Kerato epithelin antibody; LCD1 antibody; RGD CAP antibody; TGFBI antibody
-
Isotype
Rabbit IgG
-
Preparation
This antibody was obtained by immunization of TGFBI / BIGH3 recombinant protein (Accession Number: NM_000358). Purification method: Antigen affinity purified.
-
Clonality
Polyclonal
-
Formulation
PBS with 0.1% sodium azide and 50% glycerol pH 7.3.
-
Storage instructions
Store at -20℃. DO NOT ALIQUOT
-
Applications
Recommended Dilution:
WB: 1:200-1:2000
IP: 1:200-1:1000
IHC: 1:20-1:200
-
Validations

Y79 cells were subjected to SDS PAGE followed by western blot with Catalog No:116022(BIGH3 Antibody) at dilution of 1:600
Immunohistochemical of paraffin-embedded human liver cancer using Catalog No:116022(BIGH3 antibody) at dilution of 1:50 (under 40x lens)
Immunohistochemical of paraffin-embedded human liver cancer using Catalog No:116022(BIGH3 antibody) at dilution of 1:50 (under 10x lens)
Immunohistochemical of paraffin-embedded human kidney using Catalog No:116022(BIGH3 antibody) at dilution of 1:50 (under 40x lens)
Immunohistochemical of paraffin-embedded human kidney using Catalog No:116022(BIGH3 antibody) at dilution of 1:50 (under 10x lens)

IP Result of anti-BIGH3 (IP:Catalog No:116022, 3ug; Detection:Catalog No:116022 1:300) with HeLa cells lysate 1000ug.
-
Background
TGFBI, also named as BIGH3, is an adhesion protein which may play an important role in cell-collagen interactions. TGFBI was first detected in a human lung adenocarcinoma cell line after stimulation by TGF-beta (PMID: 2647740). TGFBI is secreted into the extracellular matrix (ECM) as an attachment protein. It functions mainly in cell adhesion, migration, proliferation, apoptosis, and angiogenesis. TGFBI expression is down-regulated in a variety of cancer cell lines and clinical tissue samples, and it can be used as a marker for breast cancer progression (PMID: 18425347). Defects in TGFBI have been shown to be involved in several corneal dystrophies (PMID: 18470323).
-
References
- Ma C, Rong Y, Radiloff DR. Extracellular matrix protein betaig-h3/TGFBI promotes metastasis of colon cancer by enhancing cell extravasation. Genes & development. 22(3):308-21. 2008.
- Walker G, MacLeod K, Williams AR, Cameron DA, Smyth JF, Langdon SP. Estrogen-regulated gene expression predicts response to endocrine therapy in patients with ovarian cancer. Gynecologic oncology. 106(3):461-8. 2007.
- Lin B, Madan A, Yoon JG. Massively parallel signature sequencing and bioinformatics analysis identifies up-regulation of TGFBI and SOX4 in human glioblastoma. PloS one. 5(4):e10210. 2010.
- Irigoyen M, Pajares MJ, Agorreta J. TGFBI expression is associated with a better response to chemotherapy in NSCLC. Molecular cancer. 9:130. 2010.
- Patel DA, Chang SH, Harocopos GJ, Vora SC, Thang DH, Huang AJ. Granular and lattice deposits in corneal dystrophy caused by R124C mutation of TGFBIp. Cornea. 29(11):1215-22. 2010.
- Patel DA, Harocopos GJ, Chang SH, Vora SC, Lubniewski AJ, Huang AJ. Novel CHST6 gene mutations in 2 unrelated cases of macular corneal dystrophy. Cornea. 30(6):664-9. 2011.
- Wehr AY, Furth EE, Sangar V, Blair IA, Yu KH. Analysis of the human pancreatic stellate cell secreted proteome. Pancreas. 40(4):557-66. 2011.
- Han YP, Sim AJ, Vora SC, Huang AJ. Unique TGFBI protein in lattice corneal dystrophy. Investigative ophthalmology & visual science. 52(11):8401-6. 2011.
Related Products / Services
Please note: All products are "FOR RESEARCH USE ONLY AND ARE NOT INTENDED FOR DIAGNOSTIC OR THERAPEUTIC USE"
